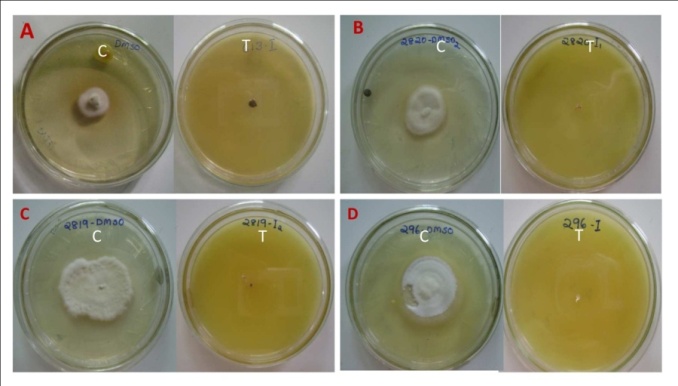
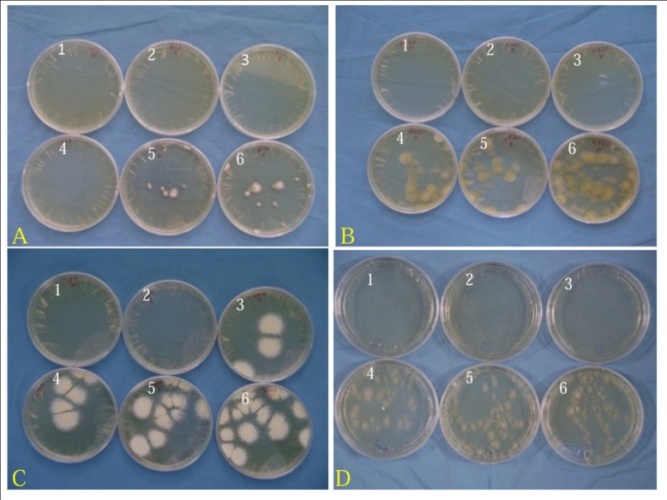

1Biochemistry and Pharmacognosy Research Lab, 2Microbiology Research Lab, School of Biosciences, M. G University, Kottayam, India
Email: mslathasbs@yahoo.com
Received: 11 Nov 2014 Revised and Accepted: 04 Aug 2015
ABSTRACT
Objective: Determination of Antidermatophytic and protease inhibiting activities of the rhizome of Zingiber zerumbet from central Kerala, India.
Methods: Dried and powdered rhizomes of Zingiber zerumbet were extracted with methanol at room temperature. Antidermatophytic activity of the extract was tested against Epidermophyton floccosum var. nigricans, Microsporum canis, Microsporum gypseum and Trichophyton rubrum by determining the percentage inhibition of mycelial growth. Minimum inhibitory concentration (MIC) and fungicidal concentration (MFC) of the extract were determined according to CLSI method–M38-A2 with slight modification. Protease inhibiting activity was analysed using trypsin as the enzyme.
Results: The methanolic extract of the rhizome of Zingiber zerumbet exhibited 100 percentage inhibition of mycelial growth of tested dermatophytes at the concentration 1 mg/ml. The inhibitory effect was statistically significant with P=0.000. MIC of the extract was 0.5 mg/ml against all organisms while MFC were 0.7, 0.8, 0.9 and 0.8 mg/ml respectively for E. floccosum, M. canis, M. gypseum and T. rubrum. The percentage inhibition of trypsin activity by 100µg, 500µg and 1000µg of the extract were 33.12±0.95, 56.34±2.82 and 72.93±1.16 respectively.
Conclusion: The rhizome of Zingiber zerumbet exhibited anti dermatophytic as well as trypsin inhibiting activity. The material is a traditionally used ingredient in food preparations. Hence it can be used for the development of less toxic medicaments for dermatophytoses and inflammatory diseases in traditional as well as modern medicine.
Keywords: Epidermophyton, Microsporum, Trichophyton, Trypsin inhibiting activity.
INTRODUCTION
Zingiber zerumbet commonly known as pinecone or shampoo ginger is a perennial herb belonging to the family Zingiberaceae. The plant is believed to be native to India [1] and is widely distributed throughout the tropical regions of Asia, Malaysia and Pacific Islands. It is used as a food flavouring agent and as an appetiser in Indian cuisines. It is being used as a traditional herbal medicine in India, Malaysia, Asia, China etc. since ancient times. Traditionally the rhizome is used to treat ailments like inflammation, pain, indigestion, constipation, stomach ache, toothache, fever, sprain, skin diseases etc [2-4]. Therefore the rhizome of Zingiber zerumbet has been the subject of many scientific studies and is reported to possess various pharmacological activities–anti-inflammatory activity [5], anti allergic activity [6], antitumour activity [7], anti-platelet aggregation activity [8], antipyretic activity [9], antiproliferative activity[10] etc. Eventhough the rhizome of Zingiber zerumbet has been used as a remedy for various skin diseases in traditional medicine no detailed studies have been reported on its activity against dermatophytes, the causative agents of dermatophytoses-a major class of skin infections.
Dermatophytoses are caused by fungi in the three genera–Epidermophyton, Microsporum and Trichophyton. These organisms are called dermatophytes. They are among the few fungi causing communicable diseases [11]. They have the capacity to invade keratinised tissues–skin, hair and nail of humans and other animals to produce infections. The varieties of clinical conditions produced by dermatophytes are collectively called tinea or ringworm. Though the infection is generally restricted to the non living cornified layers, a variety of pathologic changes occur in the host because of the presence of infectious agent and its metabolic products [12]. Dermatophytic infections are usually not serious in healthy individuals, but they cause itchy and treatment resistant lesions. Also bacteria can cause secondary infections in these skin lesions. Dermatophytoses are more serious in immunosuppressed persons. In them the infection can be more aggressive and may result in subcutaneous abscesses, disseminated diseases etc. Due to the growing number of patients with impaired immunity, the incidence of dermatophytic infections has increased considerably now days.
When compared to antibiotics, the spectrum of antifungal agents is narrow and most of the currently used antifungals have drawbacks like lack of fungicidal efficacy and various side effects like hepatotoxicity, gastrointestinal disturbances, anaemia etc. At the same time plants are considered as a tremendous source for the development of new drugs due to the chemical diversity of the compounds produced in them [13] and plant derived drugs are generally regarded as safe and free from adverse side effects [14]. Therefore when we think of the development of new antifungal agents which are effective but less toxic to humans and other animals, plants can be considered as the most appropriate source. In the present study, we have analysed antidermatophytic activity of the methanolic extract of the rhizome of Zingiber zerumbet collected from mid Kerala, India.
Trypsin inhibiting activity of the extract was also analysed which is a measure of the anti-inflammatory activity.
MATERIALS AND METHODS
Collection and extraction of rhizome
The rhizome of Zingiber zerumbet was collected from the district of Kottayam, Kerala in June 2013. The plant was authenticated by a plant taxonomist from the Department of Botany, St. Thomas College, Pala, Kerala, India. A voucher specimen (SBSBRL20) has been maintained with the author’s institute.
Collected rhizome was washed thoroughly in running tap water, cut into small slices, shade dried and powdered in a kitchen blender. Twenty five gram of powdered rhizome was extracted with 100 ml methanol at room temperature in an orbital shaker for seven days. The extract was filtered using Whatman number 1 filter paper, evaporated to dryness under reduced pressure using the rotary evaporator and kept in sterile bottle at 4 °C in a refrigerator until further use.
Test organisms
Microsporum gypseum (MTCC-2819), Microsporum canis (MTCC-2820), Epidermophyton floccosum var. nigricans (MTCC-613) and Trichophyton rubrum (MTCC-296) were used as test fungi. Microsporum gypseum and Microsporum canis were subcultured and maintained in Sabouraud dextrose agar slants while Epidermophyton floccosum var. nigricans and Trichophyton rubrum were maintained in Emmons modification of Sabouraud dextrose agar (Himedia).
The purity of standard cultures was assured by examining the morphology of macroconidia and shape and disposition of microconidia by lactophenol cotton blue staining as well as by macroscopic appearance and pigmentation of the colony on Sabouraud dextrose agar [15].
Antidermatophytic activity
The inhibitory effect of the methanolic extract of the rhizome of Zingiber zerumbet was tested by determining the percentage inhibition of mycelial growth. The dried extract was dissolved in Dimethyl Sulphoxide (DMSO) and incorporated into Sabouraud dextrose agar (SDA) plates in the concentration 1 mg dried extract/ml of medium so that the final volume of DMSO in the medium was 1%. The plates were then inoculated with mycelial discs of 6 mm in diameter cut out from the periphery of 14 days old fungal cultures. Control plates contained SDA incorporated with 1% DMSO and Griseofulvin (1 mg/ml) was used as positive control. The inoculated plates were incubated at 30 °C for 21 days and the diameter of the colony was measured. Experiments were done in triplicate and the mean diameter was determined. The percentage inhibition of mycelial growth was calculated as follows [16],
% inhibition of mycelial growth=
![]()
Three independent replications were conducted for the assay.
Minimum inhibitory concentration of the extract was determined according to CLSI (Clinical and Laboratory Standards Institute) method–M38-A2 with slight modification [17]. Sabouraud dextrose broth (Himedia MO 33) was the media used instead of RPMI 1640. Conidia and mycelia were harvested from 21 days old culture on Sabouraud dextrose agar slants, counted in a haemocytometer and adjusted to 1x104-3 x104CFU/ml with Sabouraud dextrose broth. The extract was dissolved in DMSO and serial dilutions were prepared in DMSO to hundred times the required concentrations (0.1-1 mg/ml of medium). Ten µl of various concentrations of the agents was added to tubes containing 890 µl of sterile Sabouraud dextrose broth. Ten µl of DMSO was taken for control. 100 µl of inoculum was added to each tube (final inoculum dilution 1x103-3 x103CFU/ml) and incubated at 30 °C for 3-6 days depending upon the species (until clear growth was visible in the control). Growth was read visually after the incubation and MIC was determined as the lowest drug concentration at which no visible growth was observed.
In order to determine the fungicidal activity, contents from tubes with no visible growth were sub cultured on Sabouraud dextrose agar plates (in triplicates). After mixing the contents well, 50 µl samples were drawn from each tube and spread over the surface of agar by tilting the plate. The plates were incubated at 30 °C for 7 days. The minimum fungicidal concentration was determined as the lowest concentration of extract with which all subcultures were negative.
Trypsin inhibiting activity
The assay was performed according to modified method of Alam et al., 2011 [18]. The activity was tested for 100µg, 500µg and 1000µg dry weight extract/ml of medium. Bovine serum albumin (BSA) was used as the substrate for trypsin. The reaction mixture contained 100 µg of trypsin and different concentrations of the extract, made up to 1 ml with 50 mM Tris–HCl buffer (pH 7.8) containing 1 mM calcium chloride. The mixture was incubated with 1 ml BSA (4%) at 37 °C in a water bath for 20 minutes to carry out digestion. 3 ml of 5 % TCA (Trichloro acetic acid) was added to stop the reaction, centrifuged at 2500 rpm and the absorbance of supernatant was read at 280 nm. Appropriate controls and blanks were also run. On adding TCA, un hydrolysed BSA gets precipitated and the peptide fragments formed by cleavage remain in the supernatant whose absorbance is read at 280 nm. The percentage of inhibition was calculated as,
absorbance of control
Control and tests were done in triplicate. Diclofenac sodium (1 mg/ml) was used as the positive control.
Phytochemical analysis
Preliminary phytochemical analysis of the methanolic extract of the rhizome of Zingiber zerumbet was carried out as per standard methods [19].
Statistical analysis
For trypsin inhibition assay and mycelial growth inhibition assay results are expressed as mean±SD, where n=3 (Calculated using Microsoft Office Excel 2007). Statistical significance was calculated by Student’s t test (using GraphPad software). For the determination of MIC and fungicidal activity experiments were done in duplicate and repeated independently three times [20].
RESULTS
Antidermatophytic activity
The body of filamentous fungi consists of mycelium and spores. Mycelium is the vegetative part of a fungus, consisting of a mass of branching thread-like filaments called hyphae while spores are the dormant cells. Fungal growth can be controlled by inhibiting the growth of mycelium. Mycelial growth inhibition assay is a simple but sensitive method used for the initial screening of various agents for their antifungal activity.
Results of the study of percentage inhibition of mycelial growth are shown in table 1. The percentage inhibition of mycelial growth by methanolic extract (1 mg/ml) of the rhizome of Zingiber zerumbet (MRZZ) was 100 for all dermatophytes tested (fig. 1). That is, the extract was capable of inhibiting the growth of mycelia completely in the case of all the dermatophytes tested. Hence the methanolic extract of the rhizome of Zingiber zerumbet would be highly efficient in controlling the growth of dermatophytes. The inhibitory effect of rhizome extract on the mycelial growth of dermatophytes was statistically significant with P=0.000. Percentage inhibition of mycelial growth exhibited by griseofulvin (positive control) was also 100.
Table 1: Mycelial growth inhibition assay
| Organism | Diameter of fungal colony (mean) | Percentage inhibition of fungal growtha |
| Control | MRZZ | |
| E. floccosum | 22.00 | 0 |
| M. canis | 32.20 | 0 |
| M. gypseum | 51.50 | 0 |
| T. rubrum | 45.60 | 0 |
a-Percentage inhibition of mycelial growth of dermatophytes by MRZZ-methanolic extract of the rhizome of Z. zerumbet (1 mg dry weight per ml of medium).
Fig. 1: Mycelial growth inhibition assay of MRZZ. C-control (DMSO) and T-test (extract). A-E. floccosum, B-M. canis, C-M. gypseum, D-T. rubrum
The minimum inhibitory and minimum fungicidal concentrations of the extract on the growth of the tested dermatophytes are presented in table 2. MIC values were similar for all organisms. The extract exhibited fungicidal efficacy (fig. 2) but the MFC values were slightly higher than the MIC values.
Table 2: MIC and MFC of methanolic extract of the rhizome of Zingiber zerumbet on the growth of dermatophytes
| Organisms | MIC b | MFC b |
| Epidermophyton floccosum | 0.5 | 0.7 |
| Microsporum canis | 0.5 | 0.8 |
| Microsporum gypseum | 0.5 | 0.9 |
| Trichophyton rubrum | 0.5 | 0.8 |
b–mg dry weight of extract/ml of medium
Fig. 2: Determination of fungicidal efficacy-Concentration of extract in tubes from which subculturing was done: 1-1 mg/ml, 2-0.9 mg/ml, 3-0.8 mg/ml, 4-0.7 mg/ml, 5-0.6 mg/ml, 6-0.5 mg/ml. A-E. floccosum, B-M. canis, C-M. gypseum, D-T. rubrum
Trypsin inhibiting activity
The extract exhibited significant trypsin inhibiting activity. The percentage inhibition of trypsin activity by 100µg, 500µg and 1000µg of the extract were 33.12±0.95, 56.34±2.82 and 72.93±1.16 respectively. Percentage inhibition of trypsin activity by diclofenac sodium (1 mg/ml) was 97.86±.52.
Phytochemical analysis
Result of phytochemical analysis of methanolic extract of the rhizome of Zingiber zerumbet is shown in table 3. Terpenoids, steroids, glycosides and flavonoids were the phytochemicals present in the extract.
Table 3: Phytochemical analysisc of methanolic extract of the rhizome of Zingiber zerumbet
| Alkaloids | Flavonoids | Glycosides | Steroids | Terpenoids | Saponins | Tannins | Phenolics |
| - | + | + | ++ | +++ | - | - | - |
c: +++present in abundance,++moderately present,+present in trace amounts,-absent
DISCUSSION
Traditionally medicinal plants are being used against infectious diseases successfully [21]. This study revealed the potential of the rhizome of Zingiber zerumbet to be used as an antidermatophytic agent. The methanolic extract of the rhizome was effective against all the three genera of dermatophytes. The MICs of the extract were similar against all the four dermatophytes tested. The extract was found to be fungicidal also which increases its efficiency further. Jantan et al. [22] has studied the antifungal activity of the essential oil of the rhizome of nine Zingiberaceae species including Zingiber zerumbet from Selangor, Malaysia against five dermatophytes, three filamentous fungi and five strains of yeast. But essential oil of the rhizome of Zingiber zerumbet was not effective against any of the organism at the tested concentration of 0.63-40µg/µl. Phomgpaichit et al., [23] has studied the activity of the chloroform, methanol and aqueous extracts of the rhizome of Zingiber zerumbet from Songkhlaa Province, Thailand against Microsporum gypseum (determined by disc diffusion method-1 mg per disc) but were not effective. However, the chloroform extract was active against Candida albicans and Cryptococcus neoformans. In our study, the methanolic extract of the rhizome of Zingiber zerumbet from central Kerala, India showed fungicidal activity against all the three genera of dermatophytes. This discrepancy might be due to the geographical variation in the content of rhizome. Either the antidermatophytic principle may be present only in the rhizome from this region or the relative content of the antifungal principle may be high in the rhizome collected from this region.
The methanolic extract of the rhizome of Zingiber zerumbet exhibited significant trypsin inhibiting activity also. Trypsin is a serine protease. Serine proteases are involved in a wide range of physiological processes. The effects are mediated by a family of protease activated receptors (PARS) on the cell surface. Up to date four PARS have been identified-PAR1, PAR2, PAR3 and PAR4. PAR1, PAR3 and PAR4 are activated by thrombin and PAR2 by trypsin and tryptase [24]. PAR 2 plays an important role in inflammation and pain [25]. Abnormal expression or activity of serine protease and PAR-2 is involved in many allergic & inflammatory diseases. Also exogenous proteases from allergens can activate PAR-2. Agents with protease inhibiting activity can be used to treat many such disorders. Thus agents who can inhibit trypsin (protease) can act as anti-inflammatory agents.
In dermatophytoses the fungi invade only the dead, cornified layers of the skin, nails and hair. The fungus alone has only a minimal capacity to damage skin directly. Most of the resulting pathology is caused by the host's reaction to the infecting fungus. Recovery from infection depends not only on fungal growth restriction but also on the resolution of inflammatory pathology [26]. Hence use of agents which are anti-inflammatory as well as antifungal is the emerging trend in the treatment of dermatophytoses. It has been shown that the serine protease secreted by dermatophytes cause itching through the activation of PAR 2 [27]. Hence an agent with both antifungal and protease inhibiting activity might make the treatment more beneficial and comfortable to the patient.
Phytochemical analysis showed that terpenoids were the major components present in the extract and it might be responsible for the antifungal and protease inhibiting activities exhibited by the rhizome [1]. Have reported that monoterpenes and sesquiterpenes are the major phytochemicals present in the rhizome of Zingiber zerumbet from Kerala. Zerumbone, α-Humulene, Linalool, Camphene, 1,8 Cineole, Camphor, Humulene epoxide are the major components characterised from the rhizome of Zingiber zerumbet. Further analysis is required to identify the active principle responsible for the activities.
Toxicity on prolonged use is the major problem associated with currently used antifungals. The material used in this study-the rhizome of Zingiber zerumbet is a traditionally used ingredient in food preparations. Hence the chance for it to be toxic is possibly less. Therefore the rhizome of Zingiber zerumbet from central Kerala can be regarded as a safe source for the development of new antidermatophytic agent.
CONCLUSION
Medicinal plants offer a wide chemical diversity for the development of new therapeutic agents including antifungal agents. The present study confirmed antidermatophytic and protease inhibiting activities of the rhizome of Zingiber zerumbet. Protease activated receptors and their role in inflammation is a new area of research. Blockade of PAR 2 by protease inhibitors is useful in the therapeutic control of inflammation. Since the plant exhibited excellent antidermatophytic activity along with protease inhibiting activity, rhizome of Zingiber zerumbet from central Kerala, India can be suggested as an excellent medicament in the treatment of dermatophytoses. However the development of a new drug identification of principles responsible for the activities and the elucidation of molecular basis of their action are essential and are on the way.
CONFLICT OF INTERESTS
We declare that we have no conflict of interest
REFERENCES